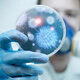
Qbp4

-
 El primer microscopio consistía en dos lentes montadas dentro de un tubo. Era posible modificar la longitud tubo y de esta forma variar la distancia entre lentes, cosa que resultaba en un distinto aumento. Con este primer microscopio era posible obtener aumentos de entre 3x y 9x.
El primer microscopio consistía en dos lentes montadas dentro de un tubo. Era posible modificar la longitud tubo y de esta forma variar la distancia entre lentes, cosa que resultaba en un distinto aumento. Con este primer microscopio era posible obtener aumentos de entre 3x y 9x. -
 Robert Hooke publicó lo que se convertiría en su obra más famosa, Micrographia ("Pequeños dibujos"). En él incluyó sus estudios e ilustraciones de la estructura cristalina de los copos de nieve y utilizó por primera vez la palabra celda (célula) para nombrar las cavidades microscópicas de panal en el corcho.
Robert Hooke publicó lo que se convertiría en su obra más famosa, Micrographia ("Pequeños dibujos"). En él incluyó sus estudios e ilustraciones de la estructura cristalina de los copos de nieve y utilizó por primera vez la palabra celda (célula) para nombrar las cavidades microscópicas de panal en el corcho. -
 Leeuwenhoek fue nombrado el "padre de la protozoología y parasitología" al descubrir el primer protozoo parásito cuando observó en su propia diarrea grandes poblaciones de Giardia Lamblia.
Leeuwenhoek fue nombrado el "padre de la protozoología y parasitología" al descubrir el primer protozoo parásito cuando observó en su propia diarrea grandes poblaciones de Giardia Lamblia. -
 El 14 de mayo de 1796, Jenner decidió inocular a un niño de ocho años llamado James Phillips un poco de materia infectada que obtuvo de una persona que padecía la viruela bovina Volvió a inocular a James Phillips, pero esta vez con viruela humana para comprobar si el niño desarrollaba la enfermedad. Los resultados le dieron la razón y el niño ni contrajo la enfermedad ni murió con lo que creo la vacuna contra la viruela.
El 14 de mayo de 1796, Jenner decidió inocular a un niño de ocho años llamado James Phillips un poco de materia infectada que obtuvo de una persona que padecía la viruela bovina Volvió a inocular a James Phillips, pero esta vez con viruela humana para comprobar si el niño desarrollaba la enfermedad. Los resultados le dieron la razón y el niño ni contrajo la enfermedad ni murió con lo que creo la vacuna contra la viruela. -
 En 1831 publicó un artículo que describía un corpúsculo intracelular al que denominó y asignó el término areola o núcleo en las células eucariotas.
En 1831 publicó un artículo que describía un corpúsculo intracelular al que denominó y asignó el término areola o núcleo en las células eucariotas. -
 El 20 de Abril 1864 se postulo el efecto pasteur que consiste en la comprensión de que organismos específicos estaban involucrados en la fermentación. Respaldada sobre la fermentación del ácido butírico lo llevaron al inesperado descubrimiento de que el proceso de fermentación podía detenerse haciendo pasar aire ( oxígeno ) a través del líquido en fermentación
El 20 de Abril 1864 se postulo el efecto pasteur que consiste en la comprensión de que organismos específicos estaban involucrados en la fermentación. Respaldada sobre la fermentación del ácido butírico lo llevaron al inesperado descubrimiento de que el proceso de fermentación podía detenerse haciendo pasar aire ( oxígeno ) a través del líquido en fermentación -
 Introdujo el concepto de homeostasis y subrayó que "la estabilidad del medio interno es una condición de vida libre".
Introdujo el concepto de homeostasis y subrayó que "la estabilidad del medio interno es una condición de vida libre". -
 Christian Gram en 1880 desarrolló la más importante tinción bacteriológica. Él desarrolló una técnica de tinción en la cual observaba bacterias en tejidos de pulmones de pacientes que
Christian Gram en 1880 desarrolló la más importante tinción bacteriológica. Él desarrolló una técnica de tinción en la cual observaba bacterias en tejidos de pulmones de pacientes que
morían de neumonía. El procedimiento que desarrolló,
ahora llamado tinción de Gram, demostró dos categorías
generales de bacterias que causaban neumonía: algunas
se teñían de violeta y otras se teñían de rojo. -
 En 1882 Koch anunció ante la Sociedad Fisiológica de Berlín que había aislado y cultivado el bacilo tuberculoso, que creía que era la causa de todas las formas de tuberculosis anunció su descubrimiento sobre el agente que provoca la tuberculosis, al cual se le llamó por un tiempo bacilo de Koch. Actualmente se llama Mycobacterium tuberculosis.
En 1882 Koch anunció ante la Sociedad Fisiológica de Berlín que había aislado y cultivado el bacilo tuberculoso, que creía que era la causa de todas las formas de tuberculosis anunció su descubrimiento sobre el agente que provoca la tuberculosis, al cual se le llamó por un tiempo bacilo de Koch. Actualmente se llama Mycobacterium tuberculosis. -
 En 1885 realizó el trabajo Das Sauerstoffbedürfnis des Organismus. Eine farbenanalytische Stuide. En el mismo formuló la teoría de las cadenas laterales aplicada a la incorporación de nutrientes específicos y puso de manifiesto otras observaciones destacadas como que la barrera hematoencefálica impedía que el cerebro tomara los colorantes vitales. Publicó varios trabajos de carácter farmacológico sobre el azul de metileno, el yodo, el alcaloide sintético 'thallin' y la cocaína.
En 1885 realizó el trabajo Das Sauerstoffbedürfnis des Organismus. Eine farbenanalytische Stuide. En el mismo formuló la teoría de las cadenas laterales aplicada a la incorporación de nutrientes específicos y puso de manifiesto otras observaciones destacadas como que la barrera hematoencefálica impedía que el cerebro tomara los colorantes vitales. Publicó varios trabajos de carácter farmacológico sobre el azul de metileno, el yodo, el alcaloide sintético 'thallin' y la cocaína. -
 El 14 de julio de 1885, el Dr. Theodor Escherich presentó sus hallazgos sobre la comuna de Bacterium coli a la sociedad en Munich (más tarde sería denomidado en su honor Escherichia coli). Que es un agente etiológico de infecciones intestinales y urinarias.
El 14 de julio de 1885, el Dr. Theodor Escherich presentó sus hallazgos sobre la comuna de Bacterium coli a la sociedad en Munich (más tarde sería denomidado en su honor Escherichia coli). Que es un agente etiológico de infecciones intestinales y urinarias. -
 En 1928, Fleming estudiaba las propiedades del Staphylococcus, un género de bacterias que está presente en la piel y la mucosa de los humanos y que causa una serie de enfermedades. Fleming cultivó cierto hongo y descubrió que producía una sustancia que inducía la muerte de varias bacterias asociadas a enfermedades.
En 1928, Fleming estudiaba las propiedades del Staphylococcus, un género de bacterias que está presente en la piel y la mucosa de los humanos y que causa una serie de enfermedades. Fleming cultivó cierto hongo y descubrió que producía una sustancia que inducía la muerte de varias bacterias asociadas a enfermedades.
Este hongo fue identificado como perteneciente al género Penicillium, por lo que, el 7 de marzo de 1929, nombró penicilina al compuesto que este produce. -
 En 1931 junto al ingeniero en electricidad también alemán Max Knoll desarrollaron el primer microscopio electrónico de transmisión (MET) para la observación de materiales.
En 1931 junto al ingeniero en electricidad también alemán Max Knoll desarrollaron el primer microscopio electrónico de transmisión (MET) para la observación de materiales. -
 La Escuela de Ciencias Biológicas nace el 19 de septiembre de 1952 bajo el amparo del Instituto de Investigaciones Científicas de la. Facultad de Filosofía, Ciencias y Letras de la Universidad de Nuevo León. Su fundador fue el Dr. Eduardo Aguirre Pequeño.
La Escuela de Ciencias Biológicas nace el 19 de septiembre de 1952 bajo el amparo del Instituto de Investigaciones Científicas de la. Facultad de Filosofía, Ciencias y Letras de la Universidad de Nuevo León. Su fundador fue el Dr. Eduardo Aguirre Pequeño. -
 Es considerado el primer neuroquímico mexicano, gracias a sus estudios en la carrera de químico, bacteriólogo y parasitólogo.
Es considerado el primer neuroquímico mexicano, gracias a sus estudios en la carrera de químico, bacteriólogo y parasitólogo.
Destaca en sus aportaciones sobre bioquímica de la nutrición y neurobioquímica. Asimismo, fue fundador de la Sociedad Botánica. -
 En 1961 debido a sus estudios superiores sobre Química, Bacteriología y Parasitología, fundó las materias de Botánica Criptogámica y Ciencias del Suelo, y en lo cual destaca uno de los trabajos más importantes de este científico mexicano fue la producción de 2 fracciones de harina integral de amaranto: (1-R) rica en proteína y (2-R) rica en almidón.
En 1961 debido a sus estudios superiores sobre Química, Bacteriología y Parasitología, fundó las materias de Botánica Criptogámica y Ciencias del Suelo, y en lo cual destaca uno de los trabajos más importantes de este científico mexicano fue la producción de 2 fracciones de harina integral de amaranto: (1-R) rica en proteína y (2-R) rica en almidón. -
 En 1965 se establece un nuevo plan de estudios de Biólogo Bacteriólogo Parasitólogo, el cual se modifica en 1968 y da lugar a la carrera de Químico Bacteriólogo Parasitólogo.
En 1965 se establece un nuevo plan de estudios de Biólogo Bacteriólogo Parasitólogo, el cual se modifica en 1968 y da lugar a la carrera de Químico Bacteriólogo Parasitólogo. -
 En 1976 junto con la investigadora Sofía Gil Lozada organizaron sesiones del grupo de Químicos en el aula de Patología al menos una vez al mes, Alvar determinaba el coeficiente de variación de las pruebas realizadas en cada laboratorio. Posteriormente, se comenzó a invitar a investigadores de otras Instituciones de Salud para que presentaran sus diferentes protocoles de investigación
En 1976 junto con la investigadora Sofía Gil Lozada organizaron sesiones del grupo de Químicos en el aula de Patología al menos una vez al mes, Alvar determinaba el coeficiente de variación de las pruebas realizadas en cada laboratorio. Posteriormente, se comenzó a invitar a investigadores de otras Instituciones de Salud para que presentaran sus diferentes protocoles de investigación -
 En 1983 el virólogo Luc Montagnier, que trabajaba en el prestigioso centro de investigación galo, publica en la revista ‘Science’ su descubrimiento: el aislamiento de un virus, el LAV-1 (lymphadenopathy virus), en su opinión posible causante del sida.
En 1983 el virólogo Luc Montagnier, que trabajaba en el prestigioso centro de investigación galo, publica en la revista ‘Science’ su descubrimiento: el aislamiento de un virus, el LAV-1 (lymphadenopathy virus), en su opinión posible causante del sida. -
 En 1997 participa en la creación de un Laboratorio de Bioseguridad Nivel 3, siendo el primero en su tipo en México.
En 1997 participa en la creación de un Laboratorio de Bioseguridad Nivel 3, siendo el primero en su tipo en México. -
 Crea el Centro regional Noreste de diagnóstico y referencia epidemiológica del País. Trabaja en colaboración con el INDRE Nacional SSA, para el aislamiento cultivo e identificación de microorganismos. (Enfermedades Emergentes).
Crea el Centro regional Noreste de diagnóstico y referencia epidemiológica del País. Trabaja en colaboración con el INDRE Nacional SSA, para el aislamiento cultivo e identificación de microorganismos. (Enfermedades Emergentes).
Looking for a timeline maker?
Create timelines for projects, roadmaps, history, lessons, legal cases, and stories with Timetoast. Timetoast is a timeline maker for work, school, research, and stories.